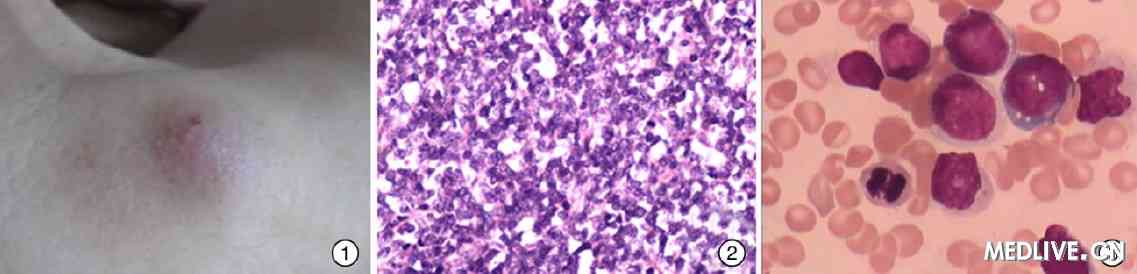
乳瘤头病毒怎么治疗_人乳瘤头病毒治疗多久_头乳瘤病毒58是什么

由于9价HPV疫苗是近年才上市的最新型HPV疫苗,各位对9价HPV疫苗的安全性还是有些疑惑,那么请看下面的内容来一一为你解答。子宫颈癌(HPV)疫苗也就是针对 HPV 病毒导致子宫颈癌而研发的预防性疫苗。目前分别有:2价、4价和9价HPV疫苗。人乳瘤头病毒治疗多久这里的价指的是预防 HPV 病毒的种类,价数越多,可以预防的 HPV 类型越多。2价疫苗针对最高危的两型(16、18 ),4价针对四型(6、11、16、18),9价针对九型(6 、11、16、18、31、33、45、52、58)。
由于9价HPV疫苗是近年才上市的最新型HPV疫苗,各位对9价HPV疫苗的安全性还是有些疑惑,那么请看下面的内容来一一为你解答。
9价HPV疫苗安全吗?
9价HPV疫苗在2014年获得美国食品药物管理局 (FDA) 核准上市,台湾、香港、澳门在2016年都通过批准上市,最新的9价HPV疫苗的安全性也已获得世界卫生组织 (WHO) 认可。截至目前(2016.12),9价加卫苗在台湾、香港、澳门并没有出现接种9价HPV疫苗发生的医疗事故,9价HPV疫苗是安全性是无需担心的。
(注意:接种前一定要和接种医生充分沟通,医生还会为你诊断是否适合接种,接种了4价HPV疫苗的同样可以继续接种9价HPV疫苗,请咨询医生意见后再决定。)
9价HPV疫苗几岁可以打?
适合接种9价HPV疫苗的年龄是在9岁以上,国外也有机构建议 11~12 岁是最佳接种年龄,没有年龄上限。不管你是否高龄、是否感染HPV病毒,接种后都能得到不同程度的保护,中国大陆媒体报道感染了HPV病毒没必要打HPV疫苗是错误的。
9价HPV疫苗只要9岁以上就可以打(国际上的共识),接种没有年龄上限,只要过了9岁越早接种效果越好。
目的分析子宫颈癌组织HPV检测的结果及相关临床资料,探讨HPV与子宫颈癌的临床生物学行为之间关系。方法收集200例有完整临床病历资料的子宫颈癌患者病灶组织,采用HPV分型基因芯片检测系统,进行HPV阳性率及其亚型的检测并对相关资料加以分析。结果HPV检出率94.0%,其中HPV16阳性率65.6%;HPV18阳性率15.5%。HPV阳性率与子宫颈癌临床分期、病理分级无相关性(P=0.25、P=0.75);HPV阳性率与肿瘤的盆腔淋巴结转移、肿瘤的治疗后复发亦无相关性(P=0.29、P=0.47);鳞状细胞癌的HPV检出率明显高于腺癌(P〈0.005)。结论子宫颈癌组织中的HPV阳性率很高,主要为16、18型。HPV感染与鳞状上皮恶变的关系更密切;HPV与宫颈癌的临床期别、病理分级、盆腔淋巴结转移、肿瘤的复发无明显相关性。
HPV病毒,又叫人乳头瘤病毒,是一种球状DNA病毒,能引起人体皮肤黏膜的鳞状上皮增殖,目前已分离出一百多种,按照其类型,可分为高危和低危两种。HPV病毒感染十分普遍,高达75%的有过性经验的男女都会感染,且极易感染,即使使用避孕套也不能全面预防。现在,唯一能预防HPV病毒的方法就是接种HPV疫苗。
每5个女性中,就有4个会感染人乳头瘤病毒
宫颈癌是一种性传染性恶性肿瘤,几乎所有的宫颈癌(99%)病例都是由人乳头瘤病毒(HPV)导致。事实上在女性一生中的某个阶段,每5个人中就有4个会感染HPV,这种病毒可在体内潜伏十年甚至更长时间,且没有任何症状。大多数HPV感染可以通过人体自身免疫系统清除,只有持续感染高风险HPV病毒才可能发展为宫颈癌。
宫颈癌的发病率很高,在港澳台地区以及海外100多个国家和地区,HPV疫苗已经使用了多年。HPV疫苗即宫颈癌疫苗。香港梅艳芳因宫颈癌而死,明星安吉丽娜朱莉切除乳腺防癌,足以让这个疫苗从医学领域走进公众视野。 什么是HPV病毒?
本文来自电脑杂谈,转载请注明本文网址:
http://www.pc-fly.com/a/jisuanjixue/article-58497-1.html
不行就是不行
奥驴黔驴技穷